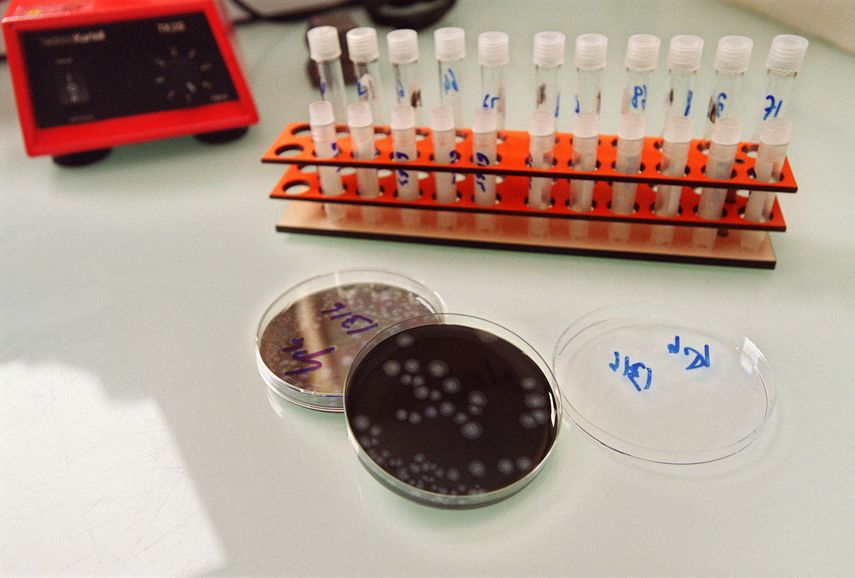
Argentina: quinta muerte por una bacteria que causa neumonía

Las muertes por neumonía a causa de la bacteria legionella se elevaron el domingo a cinco en la ciudad Argentina de Tucumán, donde 11 personas se contagiaron en un sanatorio privado, informó el ministerio de Salud de la provincia homónima.
El laboratorio de enfermedades infecciosas del estatal Instituto Malbrán identificó a la legionella como "el agente etiológico causante del brote de neumonía bilateral", según lo había revelado el sábado la ministra de Salud del gobierno nacional, Carla Vizzotti.
Tres de los restantes pacientes permanecen internados y los otros tres están "en seguimiento domiciliario", según Luis Medina Cruz, ministro de Salud de la provincia situada a unos 1.300 kms al norte de Buenos Aires.
La legionella provoca la enfermedad del legionario, un tipo de neumonía atípica muy grave con fiebre e infección pulmonar aguda.
La bacteria se transmite por vía inhalatoria a través del agua o aire acondicionado.
El agente etiológico se encuentra en ambientes de agua dulce, como lagos y arroyos. Se puede propagar a través de las cañerías o los ductos de aire.
Posibles casos de covid-19, influenza o hantavirus fueron descartados al inicio del brote.